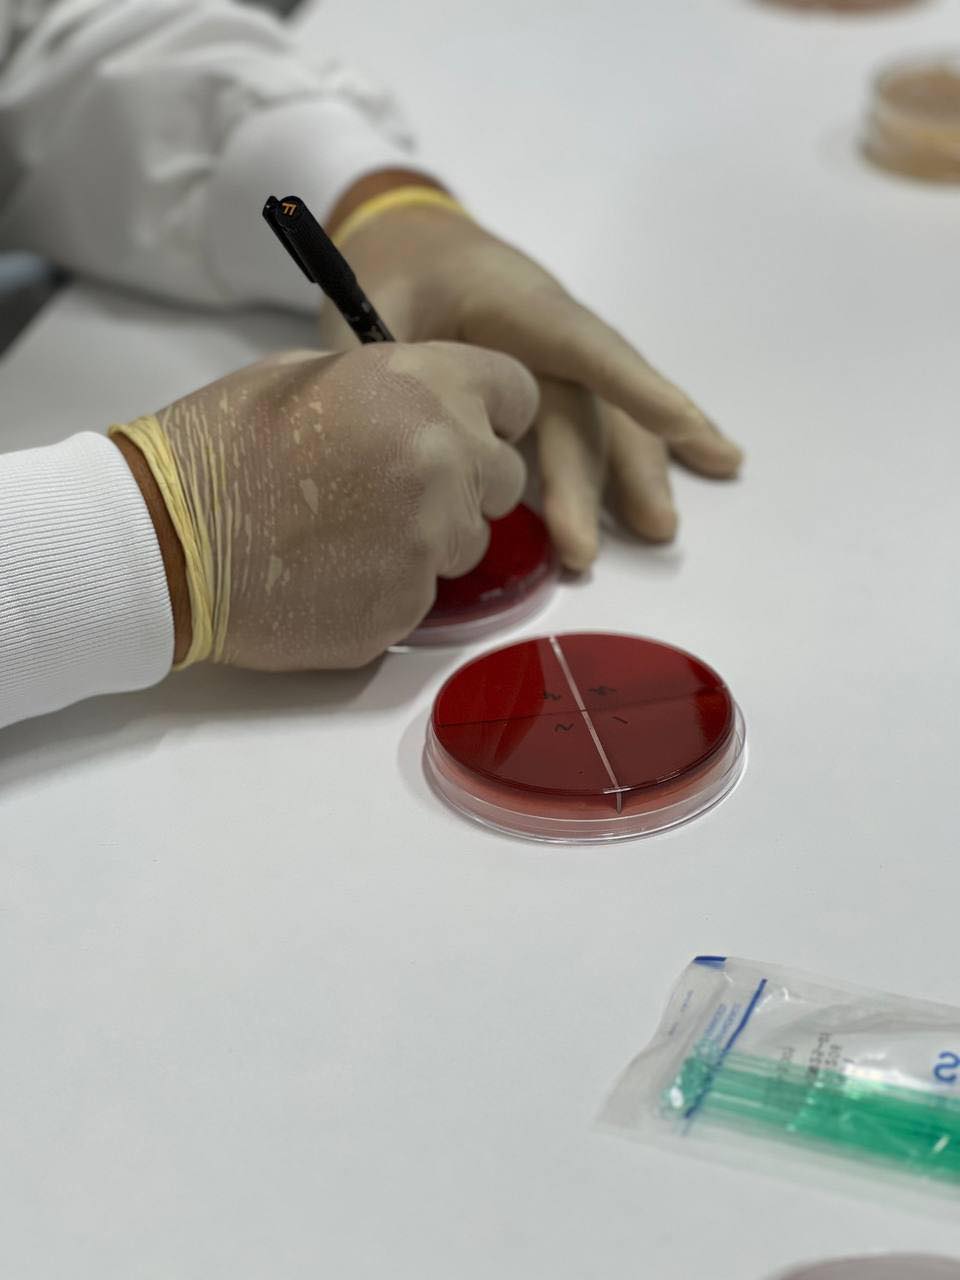

تحضير بعض انواع الاوساط الزراعية مثل MSA و الCLED و زرع انواع بكتيرية مختلفة عليها
2023-12-06 |
العلوم الصيدلانية
متابعات للجانب العملي لمقرر الاحياء الدقيقة . طرق تحضير بعض انواع الاوساط الزراعية مثل MSA و الCLED و زرع انواع بكتيرية مختلفة عليها.
جميع الحقوق محفوظة © جامعة طرابلس الأهلية 2023
برمجة وتصميم شركة طوارئ الحلول